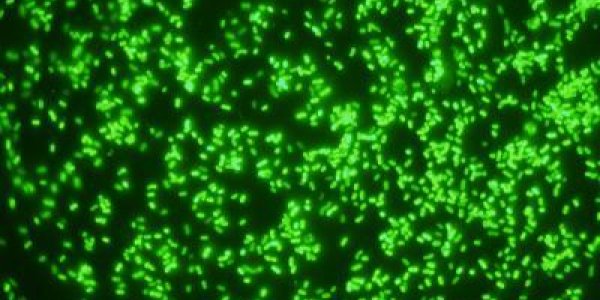
Bacteroides Ovatus Gut Bacterium A Crucial Part Of Our Daily Dietary Fiber Toolkit

Does Raw Milk Reduce Lactose Intolerance? No
Aggressive marketing by raw milk proponents has included claims that raw milk is easier to stomach for for lactose-intolerant people but a pilot study from the Stanford University School of…